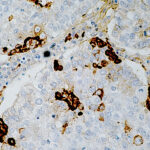

|
|---|
 Anti-Myogenin Anti-MyogeninBuy here |
 Anti-Myogenin (Myf4), Clone MGN185 Anti-Myogenin (Myf4), Clone MGN185Buy here |
 Anti-Myoglobin Anti-MyoglobinBuy here |
 Anti-Myoglobin [Polyclonal] Anti-Myoglobin [Polyclonal]Buy here |
 Anti-Myosin Heavy Chain, Smooth Muscle Anti-Myosin Heavy Chain, Smooth MuscleBuy here |
 Anti-Myosin, Skeletal Muscle Anti-Myosin, Skeletal MuscleBuy here |
 Anti-N-cadherin Anti-N-cadherinBuy here |
 Anti-Napsin A Anti-Napsin ABuy here |
 Anti-NESTIN, Clone NES/2911 Anti-NESTIN, Clone NES/2911Buy here |
 Anti-Neu, Clone 0.N.211 Anti-Neu, Clone 0.N.211Buy here |